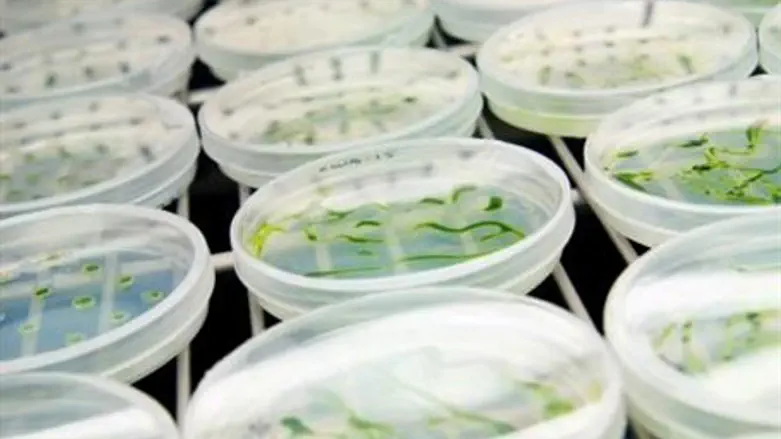
Petri dishes with developing plants and algae

Israel's Rosetta Green, a pioneer in genetic engineering to develop hardier and healthier fruits and vegetables, announced that the company had entered into a strategic research agreement to identify drought tolerance genes in corn and soybeans. Under the agreement, Rosetta Green will use proprietary technology and bioinformatics capabilities to identify microRNAs.
Discovered only in the 1990s, microRNAs (miRNAs) are unique genes that function as "main bio-switches" to control key processes in major crops such as corn, wheat, rice, soybean, cotton, canola and algae. MiRNAs are considered the “master regulators of the genome;” a single microRNA can regulate entire networks of genes. In plants, as well as in mammals, miRNAs play important roles regulating key traits and major pathways. Rosetta Green is in the business of searching out, understanding, classifying – and putting to work – these miRNA.
Using Rosetta Green's technology, DuPont, through its Pioneer Hi-Bred business, will test candidate genes in target crops. Pioneer will have an exclusive commercial license for genes identified through this collaboration which will improve drought tolerance in corn and soybeans for farmers. Financial terms of the agreement were not disclosed.
“Drought can lead to losses for corn growers of up to $13 billion annually,” said John Bedbrook, vice president, DuPont Agricultural Biotechnology. “We are pleased to collaborate with Rosetta Green to identify new genes leads which can help farmers protect yield and feed a growing population, and build on our strong pipeline of leads for drought tolerance.”
"We are greatly honored by Pioneer's decisions to work with Rosetta Green,” said Amir Avniel, Rosetta Green CEO. “Signing this agreement is a significant milestone for the company and a vote of confidence in its technology. We believe that microRNA genes have great potential in the agriculture industry and in crop improvement.”
Established in 2007, Rosetta Green started out as a subsidiary of Rosetta Genomics, and is a public company traded on the Tel Aviv Stock Exchange. Besides enhancing crops to thrive in harsh environments, the company is working on applications that enables plants use fertilizers more efficiently; currently, plants use only about 30-70% of fertilizer they are “fed” during their life cycle, with the rest turning into runoff that pollutes the water supply. If less fertilizer could be used with the same results achieved, the environment would be that much safer – and Rosetta Green has identified MicroRNAs that correlate with improved fertilizer use efficiency in corn and soybeans, with research continuing in other plants. These, along with other projects, are the core of Rosetta Genomics' technology, and with their miRNA technology, folks can hopefully look forward to tastier, healthier, and more nutritious agricultural products.